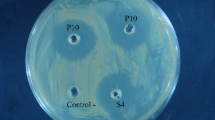

Abstract
Pursuing new probiotic targets has surged, driven by next-generation sequencing, facilitating a thorough exploration of bacterial traits. The genus Geobacillus stands out as a promising candidate for probiotics. The study explored the genetic attributes of the genus Geobacillus for their resilience to gastrointestinal conditions, nutrient production, and immunomodulatory compound creation, revealing potential probiotic traits. Predictive analyses of genomic elements like prophages, CRISPR-Cas systems, insertion sequences, genomic islands, antibiotic resistance genes, and CAZymes were conducted to assess safety. Comparative genomic analysis was performed using 18 published Geobacillus genomes and a few Lactobacillus and Bifidobacterium genomes as controls. Genes associated with probiotic traits, such as adhesion, stress tolerance (acid/bile, osmotic, oxidative), immune modulation, and molecular chaperones, were uniformly detected in Geobacillus. Mobile genetic elements (such as plasmids, prophages, and insertion sequences), virulence factors, toxins, and antibiotic resistance genes were absent, while CRISPR-Cas systems and CAZymes were present. The pan-genome comprised 25,284 protein-coding genes. Comparative genomic analysis revealed an open pan-genome for Geobacillus. Pan-genome exhibited variability, particularly in genes linked to environmental interaction and secondary metabolite synthesis. Geobacillus appears potentially safe and well-suited for the gut habitat. However, further in vitro studies are essential to confirm its probiotic potential.
Similar content being viewed by others
Introduction
The Earth encompasses unique repositories characterized by extreme environmental conditions, where some microbes, termed extremophiles, thrive with the aid of evolutionary adaptations required for survival1. The genus Geobacillus belongs to obligate thermophilic, Gram-positive rods, aerobic or facultative aerobic species thriving in the warmest regions on earth, from geothermal springs to equatorial deserts. Surviving in regions accustomed to 45–80 °C, these obligatory thermophiles possess optimum growth at 55–65 °C2,3. Their habitat remains remarkably diverse, ranging from cold environments such as Antarctica4 to extremely hot niches5. Their ability to withstand harsh temperature conditions paves their way towards numerous biotechnological applications; these species serve as key hosts for thermostable proteins with robust catalytic activity, such as amylases, protease, and lipases; and also serve various roles in bioprocessing applications such as bioproduction of biofuels and biodiesel and bioremediation2,6. Previously known to belong to the genus Bacillus, the reclassified genus Geobacillus holds immense biotechnological importance.
One of Geobacillus sp.'s major applications is biofuel production, where Geobacillus sp. are widely used to produce biodiesel (G. thermodenitrificans, G. stearothermophilus, G. thermoleovorans), isobutanol (G. thermoglucosidasius, G. thermophilus), biogas, and bioethanol (G. thermoglucosidasius, G. stearothermophilus)2. The thermophilic microbes produce bioethanol at high temperatures, with various short oligomeric and polymeric carbohydrates as substrates7. Biodiesel production is reported for lipolytic Geobacillus thermodenitrificans, using vegetable oils from kitchen oil as substrate8. A major area of its application is in bioremediation, where petroleum derivatives and crude oil wastes that are released to the environment are neutralised by thermophiles, where Geobacillus sp. was found to be a potent candidate that mesophilic bacteria for bioremediation due to more stable enzyme activity9. Furthermore, the biotechnological significance of the genus Geobacillus lies in its ability to utilise cheap and easily available substrate and convert it to byproducts, specifically with the aid of thermozymes such as amylase, xylanase, protease, lipase, and glucosidase. With the advent of research in thermophilic enzymes, Geobacillus sp. is targeted to utilizing their natural potential or by genetically engineering strains for applications in biotechnological sectors such as detergent, food, and textile industries2,3.
In food industries, thermophilic bacteria are employed as hygienic indicators of processed products utilising their ability to produce biofilms and endospores. Thermophilic Geobacillus spp. are considered major contaminants in the food industry since their presence in dairy products indicates inadequate hygiene, and consumers find high concentrations unsatisfactory. Furthermore, their growth could lead to off flavours in milk due to the production of enzymes and acids10. Furthermore, due to the ability of proteinaceous nature and lytic action, endolysins are considered to be a major candidate as food preservatives. G. stearothermophilus phages and their endolysins have been studied to explore endolysins-based antimicrobials11.
The genus Geobacillus was previously classified as a separate unit, known as group 5 of the thermophilic Bacillus, as demonstrated by a 16S rRNA gene sequencing study12. Currently, there are 20 species prescribed under the genus Geobacillus13. Research since the last century has involved the reclassification of the genus Bacillus to Geobacillus, with the earliest report of isolation of Bacillus stearothermophilus (now termed Geobacillus stearothermophilus) by Donk14. Until the end of the twenty-first century, a taxonomic study carried out by15 revealed species of B. kaustophilus, B. stearothermophilus, B. thermocatenulatus, B. thermodenitrificans, B. thermoglucosidasius, and B. thermoleovorans exhibited similar physiological and phylogenetic properties, thereby classifying these species into a new genus “Geobacillus”. With most of the species with a Gram-positive nature and few showing a Gram-variable nature, the bacteria appear in short chains and may or may not be motile. With an optimum temperature for growth at 55–65 °C, these species are obligate thermophiles and exhibit growth in neutral pH ranges (6.0–8.5)1. The nutritional profile of Geobacillus emerges as chemoorganotrophs, with oxygen as the terminal electron acceptor (with few cases showing nitrate as an electron acceptor). The species require no particular nutrients like vitamins. They can be grown in simple media such as nutrient agar, with basic requirements like carbohydrates, peptone, and tryptone as primary carbon and energy sources16. Various studies have been done to evaluate the biotechnological potential of the Geobacillus species; however, very few studies have been done on the probiotic potential of the genus Geobacillus.
Probiotics, commonly regarded as live microbes, provide health benefits through antagonistic actions against surrounding microbes17. With the global rise of antibiotic resistance18, there is a growing demand for novel strains with enhanced probiotic properties. Firmicutes, particularly Geobacillus and Parageobacillus, have attracted attention due to their secretion of antimicrobial compounds like bacteriocins, antibiotics, and bacteriocin-like inhibitory substances (BLISes), marking them as promising probiotic candidates19,20. For instance, Geobacillus thermoleovorans, isolated from oil waste, demonstrated antimicrobial activity against pathogens such as Salmonella typhimurium and Staphylococcus aureus21. These strains can also inhibit quorum-sensing in Gram-negative bacteria due to their ability to degrade Acyl Homoserine Lactones (AHLs)22. Their exceptional survival strategies, including the formation of durable endospores, enable them to thrive in extreme conditions, such as high temperatures and exposure to UV radiation, making them strong probiotic candidates for human, animal, and environmental microbiomes17,20.
Various reports suggest the prevalence of antibiotic resistance in mesophilic bacterial species, however, the phenomenon of antibiotic resistance in thermophiles is lesser known. It remains crucial to unravel the antibiotic resistance patterns and the intricate mechanism involved in thermophilic bacteria, given the immense biotechnological applications that the thermophilic bacteria impose23. Understanding antibiotic resistance in thermophiles remains crucial. Very few studies suggest the study of antibiotic-resistance profiling among thermophilic bacteria. Given this,18 researched antibiotic resistance prevailing in the microbiota of Sikkim hot springs. The culture-dependent and PCR amplification analyses revealed the absence of antibiotic resistance by the thermophilic bacteria. Similarly, no antibiotic-resistance genes were found in Geobacillus species, suggesting that the genus susceptible to antibiotics natively18. However, it is crucial to evaluate the genetic makeup of these Geobacillus species, particularly emphasizing the diverse attributes that contribute to their probiotic potential using metagenomic and pan-genomic approaches.
One of the approaches, such as standard Sanger sequencing, is well known, and over the years, numerous sequencing platforms like the next generation sequencing have emerged that employ different sequencing strategies to unravel the genomic and metabolic potential of the genome24. Genome sequencing infers to unravelling the sequences of the entire genome of an organism instead of sequencing individual genes25. The whole genome shotgun sequencing method helps understand the metabolic and genomic potential of the repertoire of genes present in an organism. Deciphering the complete genome of an organism helps to provide insight into understanding the metabolic potential, metabolomics, functional genes, and adaptive mechanisms26. For instance, the whole genome sequence of a putative novel strain of thermophilic bacterium Parageobacillus sp. indicates the presence of various important genes for carbohydrate, Sulphur, nitrogen, and phosphorus metabolism26. Another widely employed method is the metagenomic approach which helps in elucidating the diversity of microbes present and crucial genes that are responsible for conferring adaptive strategies to the microbiome, such as antibiotic resistance or stress-related genes. Functional metagenomic study on hot spring samples of Sikkim hot springs reveal diverse set of genes required to cope with stressful conditions such as heat shock, acid, and osmotic stress; various multidrug efflux pumps and transport systems, genes for degradation of xenobiotics, etc.27.
Pan-genome analyses are a powerful tool in bacterial taxonomy that may help redefine the categorization of species or, in defining new species28. The term pan-genome represents the entire set of genes present in a species and is categorized into three main categories- a core genome that comprises sequences shared between all the species; an accessory genome that represents genes shared in some species; and a singleton or unique genome that is present in a particular species only. The core genome comprises genes required for basic metabolic activities, such as genes for antibiotic resistance and housekeeping genes. These genes that are conserved usually infer evolutionary relationships amongst different strains. The genes present in the accessory genome participate in adaptive strategies in a strain, where horizontal gene transfer (thus are subjected to gene gain/loss) plays a major role that aids in coping up adaptive mechanisms in a bacterium when subjected to a new niche29. Pan-genome analysis plays a major role in implicating the evolution of the genus Geobacillus from Bacillus. There remains limited study about pan-genome analyses of the Geobacillus genus, although reports for other bacteria from the neighbouring Bacillus have been reported30. Bezuidt et al. 31 provide insights into the role of horizontal gene transfer in the diversification of Geobacillus.
This study employs an in-silico approach to assess the potential probiotic characteristics of the Geobacillus genus. It delves into various attributes, including taxonomy, phylogenomics, probiotic-related genes, prediction of antibiotic resistance genes, virulence factors, toxins, mobile genetic elements, plasmids, bacteriocins, CRISPR-Cas systems, and CAZymes. Additionally, a pan-genome analysis was conducted. To benchmark and contextualize the findings, comparative analysis involved two established genera, Bifidobacterium and Lactobacillus, serving as positive controls. Overall, this comprehensive study serves as a significant exploration of both the probiotic potential and genetic makeup of the Geobacillus genus.
Materials and methods
Genome availability and quality control
The methods have been presented in the graphical form (Fig. 1). All the 13 validly published Geobacillus species with correct names as per List of Prokaryotic names with Standing in Nomenclature (LPSN) and 5 randomly selected genomes (not validly published) of genus Geobacillus were selected and extracted in Fasta and GenBank formats from NCBI datasets https://www.ncbi.nlm.nih.gov/datasets/genome/. To evaluate the probiotic potential of various Geobacillus species, five known probiotic species were used as control strains: Lactobacillus acidophilus ATCC 9224 [NZ_CP130437], Lactobacillus delbrueckii subsp. lactis DSM 20,072 [CP022988], Lactiplantibacillus plantarum DSM 20,174 [CP039121], Bifidobacterium breve DSM 20,213 [BBAO00000000], and Bifidobacterium longum subsp. infantis ATCC 15,697 [CP001095]. After the extraction of 23 genomes, they were further analyzed for quality check, trimming, and alignment. The genome quality assessment involved utilizing QUAST (version 4.4)32. Additionally, to reconfirm genome completeness and identify any contamination, CheckM v1.0.1833 was employed, followed by trimming using the Trimmomatic program (version 0.36)34. Multiple whole genome sequence alignments were conducted using Bowtie2 v2.3.235. These analyses were performed on the KBase platform, available at https://www.kbase.us/36.
Phylogenomic analysis and annotation
The study examined the phylogenetic relationships among Geobacillus species and their connections with other Lactobacillus and Bifidobacterium probiotic genomes used in this research, based on a defined set of 49 core, universally recognized genes from COG (Clusters of Orthologous Groups) gene families. This was performed by a KBase app Species Tree Builder v0.1.436. This process begins by choosing a subset of publicly available KBase genomes that exhibit close relations to the genomes we’ve provided. Subsequently, these genomes undergo multiple sequence alignment (MSA) against 49 COG domains. The resulting alignments are meticulously refined using GBLOCKS to eliminate inadequately aligned sections within the MSA. These refined MSAs are concatenated, and a phylogenetic tree is generated using the maximum likelihood method via FastTree2 version 2.1.11. The phylogenomic analysis was also done by using the Codon Tree Test method of the phylogenetic tree-building service of Bacterial and Viral Bioinformatics Resource Center (BV-BRC) (https://www.bv-brc.org/)37. The Codon Tree approach uses the RAxML program to analyze aligned proteins and coding DNA from single-copy genes after choosing single-copy BV-BRC PGFams. RaxML’s “Rapid” bootstrapping option was used to produce support values over 100 iterations.
The genomes were annotated using Prokka v1.14.538 through the KBase platform. To assess the genes carrying known functions among the Prokka annotated genomes was done by the KBase app “View Function Profile for Genome-v1.4.0” and a heatmap was generated. It summarizes gene functions using canonical gene family assignment from COG, PFAM, TIGRFAM, and the SEED. Before this step, the domains of the Prokka annotated genomes were first annotated using the Domain Annotation app v1.0.10.36.
Detection of genes related to probiotic features
Genes involved in the mechanism of modulation of the immune system, vitamin biosynthesis, fatty acid synthesis, resistance to stress conditions (acid, bile, osmotic, and oxidative stress), adhesion, bacterial colonization, and molecular chaperones were detected from Prokka annotated genomes38. These probiotic-related genes were compared with those already known probiotic species in this study.
Detection of mobile elements, insertion sequences, plasmids, prophages, bacteriocins, and CRISPR-cas systems
The in-silico identification of plasmids among the studied genomes was done with PlasmidFinder 2.0 with default parameters of threshold for minimum % identity of 95% and minimum % coverage of 60%39. Phage presence was assessed using Phigaro through the Proksee platform with best basic mode parameters were “Black list’ penalty: −2.2, Minimum score threshold: 45.39, Maximum score threshold: 46.0, HMMSCAN E-value: 0.0044540. The characterisation of prophages was also done by detecting prophage genes coding for ARGs, VFs, and Toxins using the tools mentioned in the next section below. The mobile elements and insertion sequences were predicted by ICEFinder with Ha-value cut-off ≥ 0.6441 and VRprofile242. The putative bacteriocins were predicted by using BAGEL443, and the presence of Clustered Regularly Interspaced Short Palindromic Repeats (CRISPRs) and Cas proteins were analyzed with the CRISPRCasfinder v4.2.20 tool44 using Proksee40 platform and were also cross-checked in Prokka annotations of genomes using the KBase platform.
Detection of antibiotic resistance genes, virulence factors, and toxins
The assessment of antibiotic resistance gene predictions was conducted using ABRIcate v1.0.1 within the Galaxy platform, RGI (Resistance Gene Identifier) 6.0.3 with Loose hits of e−10 (Nudge ≥ 95% identity Loose hits to Strict), and CARD (Comprehensive Antibiotic Resistance Database)45 using PATRIC (BV-BRC v3.32.13a) and Proksee platforms. A conservative threshold was applied to identify putative ARGs, setting the amino acid identity at 30% and the comparison coverage at 70%46. The virulence factors were predicted with PATRIC (BV-BRC v3.32.13a) and ABRIcate v1.0.1 against VFDB (virulence factor database)37. The toxins were predicted with TAser (https://shiny.bioinformatics.unibe.ch/apps/taser/) using the TASmania database47. Only those genes were considered with hmm_E_value less than 1e-15.
Identification of carbohydrate-active enzymes (CAZyme)
The carbohydrate-active enzymes were identified by annotating the genome sequences through dbCAN48 with dbCAN2 HMMs of CAZy families—v10 app in KBase. This method scans protein sequences found in Genomes using a set of Hidden Markov Models (HMMs) from the dbCAN2 CAZy family collection or CAZy database (http://www.cazy.org/). It uses HMMER software v3.3.2, which is installed from http://hmmer.org.
Pangenome analysis
The Pangenome analysis was performed with Genome Comparison SDK v.0.0.7 app in KBase. The KBase algorithm for computing the protein pangenome relies on a k-mer-based approach, providing significant advantages. It entails identifying uniquely distinct k-mers, specifically of length 8, present in each protein across all genomes. Phylogenetic Pangenome Accumulation v1.4.0 (https://kbase.us/applist/apps/kb_phylogenomics/view_pan_phylo/) was run to view the pangenome in phylogenetic context and to compare among two genome sets (between Geobacillus and Lactobacillus/Bifidobacterium). This application allows to dissecting of pangenome categories using a species tree to determine the entry and exit of gene families in the branch of interest.
The Pangenome analysis was also done with IPGA (Integrated Prokaryotes Genome and Pan-Genome Analysis) v1.0949. Before any analysis quality control is done on input genomes. After QC, the genes of all filtered genomes are predicted using prokka. Using up to eight different types of software such as OrthoMCL, PanOCT, Roary, OrthoFinder, panX, Panaroo, PPanGGoLiN, and PEPPAN each gene is annotated against the COG database to provide a unique pan-genome profile. To assist users in choosing the optimal pan-genome profile from the possibly inconsistent findings, IPGA extracts all orthologous gene clusters and then assigns a score to each of them49. Pangenome Circle Plot was formed using Pangenome Circle Plot-v1.2.0 in KBase (https://kbase.us/applist/apps/kb_phylogenomics/view_pan_circle_plot/release). This app allows the overlapping membership of genes against a base genome.
Results
Source and quality check of various genomes
Among 18 Geobacillus species used in this study, 13 are validly published under ICNP as per LPSN and among 13 Geobacillus species used, 7 are type species such as Geobacillus icigianus G1w1, Geobacillus kaustophilus NBRC 102,445, Geobacillus lituanicus N-3, Geobacillus proteiniphilus 1017, Geobacillus stearothermophilus ATCC 12,980, Geobacillus thermocatenulatus BGSC 93A1, and Geobacillus thermodenitrificans DSM 465. In the case of control, probiotic species used are validly published and type species. The quality of genomes was assessed and it was shown that all the genomes possess good quality with > 97% completeness and very low fractional contamination as shown in Table 1 and Supplementary Report File 1. The GC content of Geobacillus genomes range between 49 and 53%, Lactobacillus genomes range between 34 and 49% and to that of Bifidobacterium genomes range between 58 and 60%. The total genome length of the Geobacillus genomes was higher (3.45mb–3.80mb) than those of Lactobacillus (2.03 mb–3.2 mb), and Bifidobacterium genomes (2.23 mb–2.83 mb). The isolation source of most of the Geobacillus species analyzed in this study is environmental, such as Oil fields, Hot springs, fumaroles, and sediments. However, the isolation source of Geobacillus stearothermophilus ATCC 12,980 and Geobacillus thermodenitrificans DSM 465 was food products such as spoiled canned food and sugar beet juice, respectively. On the other hand, the isolation source of other probiotic species was food and gastrointestinal tract, as shown in Table 1.
Taxonomy and phylogenomics analysis
The ANI values were plotted on a heat map Fig. 2a. The Geobacillus genomes exhibit ANI values between 90 and 100%, indicating high nucleotide identity, while Lactobacillus and Bifidobacterium genomes show lower ANI values of 60–70% in comparison to Geobacillus. Cluster analysis, illustrated by the heat map dendrogram, revealed two major clades, separating Geobacillus from the other two genera. This confirms the high nucleotide identity within the Geobacillus genus. The genus Geobacillus clade further differentiates into two main sub-clades. It was interesting to see that the earlier isolated and type species such as G. stearothermophilus, G. icigianus, G. thermodenitrificans, G. lituanicus, G. uzenensis, and G. subterraneus possess slight variation in ANI values than the recently isolated genomes which are not validly published. The phylogenetic analysis among the genomes of only the genus Geobacillus shows a similar pattern with two major clades, and three separate clades have been formed by G. icigianus, G. jurassicus, and G. vulcani Fig. 2b.
(a) Heatmap showing ANI values between the studied genomes of genus Geobacillus and two other genera such as Bifidobacterium and Lactobacillus. (b) Phylogenetic tree of genus Geobacillus based on the whole genome with an out-group of genus Bacillus. (c) Phylogenetic tree showing the relation among genus Geobacillus and two other probiotic species of genus Lactobacillus and Bifidobacterium based on COG-based core genes. (d) Phylogenetic tree based on single-copy genes using single-copy BV-BRC PGFams showing the relation among Geobacillus and two other probiotic species of genus Lactobacillus and Bifidobacterium.
We were also trying to find out the phylogenetic relation among the genus Geobacillus and two other probiotic species of genus Lactobacillus and Bifidobacterium based on COG-based core genes Fig. 2c and Supplementary Fig. 1 and single copy genes using single-copy BV-BRC PGFams. The phylogenetic tree, established using a set of 49 core universal genes defined by COG, indicates the emergence of two primary clades encompassing the genus Geobacillus as well as the genus Lactobacillus and Bifidobacterium. The genus Geobacillus further differentiates into two sub clades. In contrast, species G. jurassicus, G. vulcani, and G. icigianus form separate clades similar to the phylogenetic tree of only the genus Geobacillus based on ANI values. The genus Lactobacillus closely relates to Parageobacillus species, whereas Lactobacillus and Bifidobacterium are distantly related to the genus Geobacillus as they possess separate clades. Similar results were demonstrated by a phylogenetic tree based on single-copy genes, as shown in Fig. 2d. However, based on these genes, Lactobacillus forms a clade close to G. icigianus, and other earlier isolated genomes such as G. stearothermophilus, G. thermodenitrificans, G. lituanicus, and G. subterraneus. Thus, based on core gene phylogenetic analysis of Geobacillus, Lactobacillus, and Bifidobacterium genomes, it has been shown that they significantly differ which is further supported by phylogenetic analysis based on single gene analysis.
The relationship between Lactobacillus and Parageobacillus is closer than their relationship to Geobacillus. This is because Lactobacillus and Parageobacillus share more genetic similarities, often clustering in closer proximity within phylogenetic trees or clades. On the other hand, Lactobacillus and Bifidobacterium are more distantly related to Geobacillus and tend to form separate clades, indicating a more significant evolutionary divergence between them and Geobacillus. The separation into distinct clades reflects their differences in nucleotide identity and genetic characteristics.
The functional assessment (subsystem analysis) among the genomes using canonical gene family assignment is represented in Heatmap Fig. 3. It has been shown that subsystems like secondary metabolites biosynthesis, transport, catabolism, intracellular trafficking, secretion, chromatin structure and dynamics, cytoskeleton, and RNA processing and modification were uncharacterized in all the genomes. However, there is not much difference in other characterized subsystems between genomes of the genus Geobacillus, Lactobacillus, and Bifidobacterium. Cell motility is absent in the genus Lactobacillus and Bifidobacterium whereas in the genus Geobacillus. Moreover, slight differences exist in a few subsystems among the studied genus, such as Energy production and conversion, lipid transport, and metabolism. This signifies that there might be similarities among these genera considering probiotic properties.
Identification of genes related to probiotics
Genes involved in the mechanism of modulation of the immune system, vitamin biosynthesis, fatty acid synthesis, resistance to stress conditions (acid, bile, osmotic, and oxidative stress), adhesion, bacterial colonization, and molecular chaperones were detected. The predicted genes among all these categories are present differently in Table 2. 25 genes of immune system modulation were screened and genes such as Pyrc, PyrE, PyrH, PyrB, PyrG, PyrK, TxrA, TxrB, Clpb, CysC, nrdR are present in all the genomes whereas CysE, YjbK, and YjbM were present only in Geobacillus genomes and nrdH and dltC are present only in Bifidobacterium and Lactobacillus genomes. 25 genes of adhesion were screened and genes such as Tuf, clpB, clpX, and clpC are present in all the genomes. comC, srtD, PilT, PilZ, and lapA are present in only the Geobacillus genomes, whereas dltD and dltA were present in Bifidobacterium and Lactobacillus genomes only. Three sortase genes such as strA1, strA2, and strA3, were absent in all genomes except srtA1, which was present in Lactobacillus genomes only. Also, PilA, PilB, PilC, PilO, and PilM adhesion genes were absent in all the genomes. Six bacterial colonization genes were screened, and only gene TadA was present in all the genomes rest were absent such as TadB, TadC, TadE, TadF, and TadZ. All the acid stress-related genes such as atpB, atpC, atpD, atpE, atpF, atpG, atpH, recA, sodA, luxS, glmU, glmS, glmM1, glmM2 and asps were present in all the genomes whereas cspA and gpmA were only present in Bifidobacterium and Lactobacillus genomes. Some acid resistance genes such as gpmL, bshA, bshB, and bshC were only present in Geobacillus genomes. 8 bile resistance genes such as nagB, pyrG, argS, rpsC, rpsE, rplD, rplE, and rplF were present in all the genomes. Osmotic stress-related genes were absent in Bifidobacterium and Lactobacillus genomes, however, opuD and opuC were present in some Geobacillus genomes, and opuCA, opuCB, and opuCC were only present in Geobacillus genomes. Molecular chaperones such as dnaK, dnaJ, and dnaG were present in all the genomes whereas groES and groEL were present in some Geobacillus genomes only. 18 genes related to oxidative stress were screened and among them taxA. TaxB, feoB, and msrC were present in all the genomes, whereas ndhH, ndhB, and ndhC were present only in Geobacillus genomes and msrB only in Lactobacillus. 7 genes related to vitamin biosynthesis were screened and genes BtuD, copA, and copZ were present in all the genomes, whereas BtuF and CsoR were only present in Geobacillus genomes. Principle component analysis was done based on all the parameters (genes) related to probiotics including antibiotic resistance genes. The Principle component 1 (PC1) significantly shows the positive correlation between Bifidobacteria and Lactobacillus genomes and their relatively less positive correlation with the genomes of Geobacillus as shown in Fig. 4.
Assessment of antibiotic resistance genes, virulence factors, and toxins
The presence of antibiotic resistance genes was anticipated within the genomes under investigation. It was shown that only a few antibiotic-resistance genes such as vanY, vanT, and rpoB were present in all the genomes. However, other genes like ImrD, rpsL, and qacJ were present in Lactobacillus genomes as shown in Table 3. None of the toxin-related genes were present in Geobacillus, Lactobacillus, and Bifidobacterium genomes. Only a few toxin-like proteins, such as PhoH, MazF, HicA, and PemK genes, were predicted in some Geobacillus genomes. However, many genes coding toxins such as FitB, PemK, MazF, ParB, RelB, RelE, MraZ, YoeB, PhoH, and HipA toxin-related genes were present in genus Bifidobacterium and Lactobacillus species as shown in Table 4. No virulence factors were found in any genomes studied as shown in Table 3.
Assessment of mobile genetic elements, insertion sequences, plasmids, prophages, bacteriocins, and CRISPR-cas systems
Mobile genetic elements were absent in all genomes except a few mobile elements present in B. brevis such as IS/Tn. Putative insertion sequences were present in many Geobacillus, Lactobacillus, and Bifidobacterium genomes such as Putative IME, Putative ICE with T4SS, and Putative IME without identified DR as shown in Supplementary Table 1. Plasmids were found to be absent in all the genomes Table 3. Many bacteriocins such as Circularin_A, ComX1, ComX4, Salivaricin_D, Sactipeptides, Pumilarin, and Geobacillin_I_like were present in various genomes of Geobacillus like G. icigianus, G. kaustophilus, G. lituanicus, G. C56T3, G. stearothermophilus, G. thermocatenulatus, G. vulcani, etc. However, among the two Bifidobacterium genomes, only B. longum possesses a few bacteriocins such as Geobacillin_I_like and Propionicin_SM1. Moreover, Lactobacillus genomes possess different bacteriocins than that of Geobacillus and Bifidobacterium genomes such as Plantaricin_E/F/A/N/J/K, Enterocin_X, Acidocin_J1132, Enterolysin_A, and Bacteriocin_helveticin_J as shown in Table 5. Among 18 Geobacillus genomes, 11 possess prophages mainly within the family of Myoviridae and Siphoviridae. Similarly, Bifidobacterium and Lactobacillus possess prophages mainly from the family of Siphoviridae shown in Table 6. Further characterization of prophages was done to detect the genes coding for any antibiotic resistance, virulence factors or toxins. The results show that none of the prophages code for antibiotic resistance and toxins. Similarly, none of the prophage codes for virulence factors except the one found in Geobacillus_sp._C56-T3__NC_014206. The prophage was found to code for three virulence factors related to heat shock proteins. Two virulence factors (VFG001855 and VFG010485) with genes corresponding to htpB code for heat shock protein Hsp60 and Chaperone Cpn60, respectively, have been possibly integrated from Legionella pneumophila. The third virulence factor (VFG012103) has a gene encoding for groEL chaperonin and is integrated from Clostridium thermocellum ATCC 27405. CRISPR-Cas Systems was found to be present only in Geobacillus genomes. Cas1, Cas2, Cas3, Cas4, Cas5h, Cas6, Cas9, Cmr1, Cmr3, Cmr4, Cmr5, and Cmr6 are present in many Geobacillus genomes such as G. icigianus, G. thermoleovorans, G. uzenensis, G. stearothermophilus, G. subterraneus, and G. jurassicus etc. However, CRISPR-Cas Systems were found to be absent in Bifidobacterium and Lactobacillus genomes as shown in Table 2.
Identification of carbohydrate-active enzymes (CAZyme)
Carbohydrate-active Enzymes (CAZyme) were found to be present in almost all genomes. Glycoside hydrolases were present in abundance and various glycoside hydrolase classes such as GH1, GH13, GH13_1, GH13_2, GH13_4, GH13_4, GH13_10, GH13_12, GH13_13, GH13_14, GH13_20, GH13_21, GH13_23, GH13_29, GH13_31, GH13_36, GH13_37, GH13_39, GH13_41, and GH18 were present with more than 2 hits or genes present. Among Glycosyl transferases GT2, GT4, GT51, and GT108 were present with more than 2 hits. CBM34 and CBM68 are present with more than 2 hits. CE4 and CE9 were the carbohydrate esterases present with more than 2 hits. Polysaccharide lyases were absent in all the genomes. AA1 and AA1_3 were CAZymes with Auxiliary activities having more than 2 hits. The above-mentioned CAZymes (except Polysaccharide lyases) were present in all the genomes as shown in Heatmap Fig. 5.
Pangenome analysis
The total number of genomes studied in the pangenome was 23, and among them, 18 were Geobacillus species, 3 were Lactobacillus species, and 2 were Bifidobacterium species. The pan-genome analysis was done within the genus Geobacillus alone and with other genera like Lactobacillus and Bifidobacterium. The pan-genome analysis of all 23 genomes represented 38393 protein-coding genes (with translation), 30702 genes in homolog families, and 7691 genes in singleton families. The total number of families was 11637, 3764 were homolog families, and 7873 were singleton families. When taking the pan-genome analysis of only the genus Geobacillus into consideration, the pan-genome represented 25284 protein-coding genes (with translation), 23504 genes in homolog families, and 1680 genes in singleton families. The total number of families was 4641; 2813 were homolog families, and 1828 were singleton families Supplementary Table 2. The core pangenome rarefaction curve of the genus Geobacillus shows the increasing number of gene clusters with every added genome. Thus, this shows that the Geobacillus pan-genome is an open pangenome as shown in Fig. 6a. The pangenome circle plot was contrived to plot the core, non-core, and singletons. The circle plot of the genus Geobacillus shows larger core genes than that of singletons shared between the genomes, whereas when the circle plot was made between Geobacillus, Lactobacillus, and Bifidobacterium genomes, they shared very few core genes, as shown in Fig. 6b,c, Supplementary Figs. 2, 3. Phylogenetic Pangenome Accumulation was run to view the pangenome in a phylogenetic context and to determine the entry and exit of gene families in the branch of interest. The Phylogenetic Pangenome Accumulation tree shows the bifurcation of two main clades as shown in the phylogenetic trees discussed above. Node zero was important as it bifurcates into two main clades with node 1 (gives rise to genus Bifidobacterium clade) and node 6. Node 6 was also important as it bifurcates into two separate branches of the genus Geobacillus as one clade and the genus Lactobacillus as another clade. At node zero, there was the maximum number of total genes present (17392) with a very less perfect core of only 0.8%. there is the accumulation of genes at node 1 for genus Bifidobacterium with an increase in perfect core of 27.3%. Similar to node zero there was the second maximum number of total genes (14861) (as the rest of the genes got accumulated into genus Bifidobacterium) with a very small perfect core of only 1.6%. This total gene numbers gradually accumulated and showed the increase in perfect core as shown at node 18 (with the perfect core of 8.6%) for the genus Geobacillus and at node 7 (with a perfect core of 8.9%) for the genus Lactobacillus. These genes further get accumulated within sub-branches as shown in Fig. 7.
(a) Rarefaction curve representing the Pan-genome core plot of the genus Geobacillus. (b) Pan-genome circle plot comparing the genomes of genus Geobacillus representing core, singleton, and accessory genomes. 0 = G. stearothermophilus, 1 = G. jurassicus, 2 = G. kaustophilus, 3 = G. sp. C56-T3, 4 = A = G. icigianus, 5 = G. proteiniphilus, 6 = G. sp. GHH01, 7 = G. sp. Y412MC52, 8 = G. thermodenitrificans, 9 = G. thermoleovorans, 10 = G. uzenensis, 11 = G. sp. CAMR5420, 12 = G. subterraneus, 13 = G. lituanicus, 14 = G. vulcani, 15 = G. sp. LEMMJ02, 16 = G. zalihae, 17 = G. thermocatenulatus. (c) Pan-genome circle plot comparing the genomes of genus Geobacillus, Bifidobacterium, and Lactobacillus representing core, singleton, and accessory genomes. 0 = G. stearothermophilus, 1 = G. jurassicus, 2 = G. kaustophilus, 3 = G. sp. C56-T3, 4 = A = G. icigianus, 5 = G. proteiniphilus, 6 = G. sp. GHH01, 7 = G. sp. Y412MC52, 8 = G. thermodenitrificans, 9 = G. thermoleovorans, 10 = G. uzenensis, 11 = G. sp. CAMR5420, 12 = G. subterraneus, 13 = G. lituanicus, 14 = G. vulcani, 15 = G. sp. LEMMJ02, 16 = G. zalihae, 17 = G. thermocatenulatus. 18 = B. breve, 19 = B. longum, 20 = L. plantarum, 21 = L. acidophilus, 22 = L. delbrueckii.
Discussion
The species of the Geobacillus genus exhibit ecological, physiological, and genetic diversity merely due to micro-evolutionary traits such as horizontal gene transfer, which remains a strong factor contributing to the evolution of Bacillus to Geobacillus31. Thriving in harsh conditions, thermophiles have been exploited in various industrial and biotechnological applications. However, only a few studies suggest the probiotic nature of the species belonging to the genus Geobacillus. Here, we have presented the vast in silico evaluation of the genus Geobacillus considering its probiotic nature. The analysis has been done in genus Geobacillus keeping already known probiotic strains of genus Lactobacillus and Bifidobacterium as positive controls. Various characteristics studied so far to claim any probiotic species have been covered in this study.
Taxonomic and phylogenetic studies, based on genome comparisons, showed high nucleotide identity within Geobacillus species, supporting their current classification. This is consistent with prior phylogenetic studies of Geobacillus50. Using core genes (COG-based and single-copy PGFams), phylogenetic analyses also clearly separated Lactobacillus and Bifidobacterium into distinct groups, confirming their established classifications. The annotation results using Prokka suggested that the subsystems highly represented were replication, recombination, repair; post-translational modifications, protein metabolism, and chaperones; nucleotide transport and metabolism; signal transduction mechanism; general functions; energy production and conversion; translation, ribosome structure, and biogenesis; carbohydrate metabolism, amino acid metabolism, and transcription. Whereas the unrepresented features were secondary metabolites biosynthesis, transport, catabolism, intracellular trafficking, secretion, chromatin structure and dynamics, cytoskeleton, and RNA processing and modification. Our research shows that while most functional categories are found in the core genome, the flexible genome (accessory and singleton genes) also contains a significant number. Comparative analyses revealed that essential housekeeping genes and key functional classes are consistently present within this core genome. Conversely, genes involved in environmental interactions and secondary metabolite production were more common in the pan-genome. Also, the considerably flexible genome percentage reveals that horizontal gene transfer (HGT) could represent a crucial mechanism contributing to the environmental adaptive characteristics observed in the genus Geobacillus.
Similar findings were reported by Bezuidt et al. in 2016, indicating an overabundance of genes related to COG categories including translation, ribosomal structure, coenzyme transport and metabolism, nucleotide transport and metabolism, as well as protein turnover and chaperones within the conserved core31. In a study conducted by Wang et al. in 2020, detailed comparative analyses indicated that core genome stability persisted in fundamental functional classes and essential housekeeping genes, while the flexible genome exhibited a higher prevalence of genes associated with environmental interaction or energy metabolism. Furthermore, horizontal gene transfer (HGT) instances were identified among various Geobacillus species; thus, the Geobacillus evolution appears to be influenced by environmental factors51.
As in our study, we found that secondary metabolite metabolism is mainly confined to a flexible genome. Thus, to evaluate this metabolite potential is very important for industrial and biotechnological applications. Wang et al., 2020, show that various genes for starch, arabinose, glucose, mannose, galactose, and xylose metabolism were also observed in the pan-genome, with a high occurrence of ABC-type sugar transporters that aid in sugar uptake. Therefore, the pan-genome analyses in Geobacillus reveal it as a good candidate for hemicellulose degradation51. A similar overrepresentation of the genes was observed in a study conducted by31 on pan-genome analyses of 29 Geobacillus genomes, depicting that such diverse metabolic machinery aids in its diverse biotechnological potential.
There are various measures for the assessment of any species to be probiotic. The FAO and WHO (2002) guidelines, alongside regulations from the Food and Drug Administration and the Ministry of Public Health in Thailand, delineate the criteria for utilizing probiotic microorganisms in food. These standards encompass specific criteria such as accurate identification, evaluation of probiotic characteristics (such as resistance to gastric acid and bile salts, adherence to mucosal surfaces and epithelial cells, and bile salt hydrolase activity), and a safety assessment encompassing factors like antimicrobial resistance (AMR), toxin production, and hemolytic activity52,53. We have evaluated and covered almost all the characteristics of genus Geobacillus to assess its probiotic potential concerning genus Lactobacillus and Bifidobacterium. Genes related to tolerance to various stress conditions, adhesion, colonization, immune response, etc., governing the probiotic potential were determined. Several genes associated with adhesion, such as srtD, clpB, and clpC, were identified, potentially playing a role in binding to cells or mucosal surfaces within the gut54,55. Other genes such as TadA, PilT, PilZ, and lapA are essential for pili structure, and thus bacterial colonization was found in the genus Geobacillus56. The key feature defining a bacterium as a probiotic strain hinges on its ability to survive, adapt, or resist low-pH environments57. Studies suggest that probiotic microorganisms harbour particular genes that aid in enduring or resisting adverse conditions57. Moreover, more than fourteen immune-modulatory genes related to immune response in Geobacillus species were detected. The pyrC, pyrE, pyrH, pyrB, pyrG, and pyrK genes play key roles in the pyrimidine biosynthesis pathway, essential for nucleotide production and bacterial survival. In Francisella novicida, pyrC encodes dihydroorotase, and its deletion increases pro-inflammatory cytokines (TNF-α, IL-1β, IFN-β), indicating its role in suppressing host immune responses58. pyrE, encoding orotate phosphoribosyltransferase, impacts bacterial growth and virulence, indirectly influencing immune modulation59. pyrH, which encodes UMP kinase, affects bacterial virulence by impairing pyrimidine biosynthesis60. pyrB encodes aspartate carbamoyl transferase, and mutations in Pseudomonas aeruginosa reduce virulence factor production, altering host immune responses61. pyrG, responsible for converting UTP to CTP via CTP synthase, impacts bacterial growth and immune modulation when disrupted62. Lastly, pyrK is regulated by PyrR in Mycobacterium smegmatis, and its proper expression is crucial for bacterial survival and pathogenicity, indirectly influencing host immunity63. clpB plays a significant role in maintaining neutrophil levels and proper immune function. Severe congenital neutropenia is characterized by severe shortage of neutrophils which are vital elements in innate immunity. The clpB mutations are known to disturb granulocytic differentiation and function of the mitochondria resulting in elevated rates of apoptosis in hematopoietic progenitor cells64. Cystatin C, gene product of CysC, is an inhibitor for cysteine protease, which modifies immune reactions by controlling the activity of cathepsins. Silencing of cystatin C in human macrophages increases the intracellular killing of M. tuberculosis, upregulates proteolytic activity of cathepsins, and enhances HLA class II expression. This results in increased CD4 + T-lymphocyte proliferation and the secretion of IFN-γ65. Furthermore, cystatin C suppresses the expression of pro-inflammatory cytokines like interleukin-1β and tumor necrosis factor-α, which shows its involvement in regulating inflammatory responses66. CysE gene encodes for serine acetyltransferase. In Escherichia coli, CysE affects the activity of extracellular signals that modulate biofilm formation, and the latter has been shown to be related to immune evasion. Biofilm formation was enhanced by the loss of CysE; this suggests its involvement in controlling factors that impact the host immune system interaction of the bacterium67. The YjbM gene in Bacillus subtilis encodes a GTP pyrophosphokinase that acts as a (p)ppGpp synthase, synthesizing guanosine tetra- and pentaphosphate—alarmone molecules integral to the stringent response. This response allows bacteria to adapt to environmental stresses by modulating various physiological processes, including virulence factor production and biofilm formation, which can influence interactions with the host immune system68. The nrdH gene encodes a component of the ribonucleotide reductase complex, which is necessary for DNA synthesis and repair. Specific studies on the role of nrdH in immune modulation are scarce, but its involvement in DNA metabolism implies a potential influence on immune cell proliferation and function. Disruptions in DNA synthesis pathways can affect lymphocyte development and response, thereby impacting the adaptive immune system. Further research is necessary for the detailed role of nrdH in immune modulation69. The dltC gene encodes a protein that participates in the d-alanylation of teichoic acids in bacterial cell walls, which is a process that enhances cell wall integrity and resistance to host immune defense70. The dltC gene has also been reported to be differentially expressed in tolerogenic dendritic cells, which have been known to participate in immune regulation and tolerance71.
The probiotic potential of Geobacillus species can be influenced by key genes involved in survival, stress adaptation, and immune modulation. Genes from the pyrimidine biosynthesis pathway, such as pyrC and pyrG, ensure robust bacterial growth and modulate host immune responses. Stress response genes like clpB support bacterial resilience and neutrophil regulation, while YjbM aids environmental adaptation through stringent response. Biofilm formation, regulated by CysE, helps bacterial colonization, though excessive biofilms may hinder host interactions. CysC reduces inflammation by controlling cathepsin activity and cytokine expression, contributing to gut health. Genes like nrdH and dltC enhance DNA repair and cell wall integrity, improving bacterial survival against host defence. Additionally, dltC is linked to tolerogenic immune responses, promoting immune tolerance. These genes optimize Geobacillus strains’ ability to persist in the gut, modulate immunity, and maintain microbiome balance, making them promising probiotic candidates.
Lactobacillus strains typically exhibit resilience to acid and bile, allowing these bacteria to endure and adjust to harsh conditions, rendering them promising candidates for probiotic applications72. Here, we have detected various genes for acid and bile resistance in the genus Geobacillus, such as sodA, luxS, glmU, atpH, recA, etc. The F1F0-ATPase, encoded by the atp operon, typically comprises genes—namely, atpB, atpE, atpF, atpH, atpA, atpG, atpD, and atpC—in most microbes73. Most of these genes were identified in the Geobacillus genome. These atp genes enable host microorganisms to survive or withstand acidic environments. The main role of the "atp" operon is to facilitate proton pumping, transporting protons from the bacterial cytoplasm outward and contributing to the maintenance of a neutral pH in the bacterial cytosol74.
In response to hyperosmotic stress, organisms accumulate osmotically active compounds. These compounds, known as compatible solutes, do not hinder enzymatic processes within the cell. The gathering of these solutes, known as osmoadaptation, works to counter the outward movement of water, thereby maintaining cell turgor75. Numerous thoroughly characterized compatible solute transporters have been detected in various Gram-positive organisms, such as Bacillus subtilis and Lactococcus lactis. OpuA, OpuB, and OpuC belong to the ATP binding cassette (ABC) superfamily and are closely associated transporters. These transporters have the capability to transport distinct compounds: OpuA transports proline betaine and glycine betaine, OpuB transports choline, while OpuC transports ectoine, crotonobetaine, γ-butryobetaine, carnitine, choline-O-sulfate, choline, proline betaine, and glycine betaine76. These osmotic stress-related genes were absent in Bifidobacterium and Lactobacillus genomes, however, opuD and opuC were present in some Geobacillus genomes, and opuCA, opuCB, and opuCC were only present in Geobacillus genomes. Genes related to oxidative stress such as thioredoxin (trx), and ferrous iron transporter (feoB) were present in almost all the genomes. However, transcriptional regulator (oxyR), and NADH (ndhH, ndhB, and ndhC) were present only in Geobacillus genomes. These genes are associated with antioxidant and oxidative stress responses in many bacteria77,78.
The genes responsible for encoding chaperones (dnaK, groEL, groES) play a crucial role in a broad stress response, involving protection, elimination of damaged proteins, and various related functions. Additionally, the analysis revealed dnaJ and grpE, which have demonstrated a responsive behavior (upregulation) specifically to acidic environments79. All the genomes examined contained these molecular chaperones. However, groES and groEL were present in some Geobacillus genomes only. The presence of these probiotic-related genes in the genus Geobacillus makes them a promising candidate for exploiting them as probiotic strains. However, culture-dependent analysis of these probiotic features must be validated.
Analyzing the mobilome offers a deeper comprehension of genome stability, adaptability, and evolution in host probiotics, particularly in evaluating the potential acquisition and transfer of new genes, including those linked to antibiotic resistance. Nevertheless, if a probiotic strain’s genome harbors mobile genetic elements (MGEs) along with antibiotic resistance genes, it becomes unfit for use due to the risk of transferring these resistance genes via processes like conjugation or other mechanisms80,81. The lack of mobile genetic elements, virulence factors, and minimal putative insertion sequences indicates the stability of the genus Geobacillus, potentially making it favorable for probiotic candidacy. Regarding the anticipated prophages found in Geobacillus genomes, only a small number belonging to the Myoviridae and Siphoviridae families were identified. However, most of these were hypothetical and lacked the typical genes responsible for encoding structural proteins, DNA regulation, lysis, and other essential functions as per the Prokaryotic Virus Orthologous Groups (pVOGs) database. Consequently, these could be classified as defective prophages82. Pei et al. (2024) conducted a study exploring the extensive diversity of prophages derived from the human gut, shedding light on previously hidden viral contributors to intestinal microecology. In their study they found high probabilities of complete prophages in common probiotic species: Lactiplantibacillus plantarum (94.2%), Lacticaseibacillus paracasei (93.9%), and Lacticaseibacillus rhamnosus (89.7%). Other species, including Lactococcus lactis, Limosilactobacillus reuteri, Ligilactobacillus salivarius, and Lactobacillus gasseri, also showed elevated prophage content. In contrast, Bifidobacterium species rarely harboured prophages or prophage regions. These findings were similar to our findings, where we found more prophages in lactobacillus species than in bifidobacterial species. The study led by Pie et al., 2024 also revealed that Lactobacillus played a significant role in detecting prophage-associated antimicrobial resistance genes (ARGs). Additionally, both lactobacilli and bifidobacteria exhibited a higher prevalence of prophage-associated virulence factor genes (VFGs). Analysis identified 332 exotoxin-related VFGs linked to prophages across the genomes of 323 bacterial strains from 16 widely used probiotic species83. These findings indicate that commonly used lactobacilli may present a significant risk of prophage transmission within the human gut. The presence of prophage-associated antimicrobial resistance genes (ARGs) suggests that prophages play a crucial role in the spread of ARGs among lactobacilli. Likewise, the detection of virulence factor genes highlights additional potential risks, underscoring the broader implications of prophage activity in probiotic strains. In contrast, our study found none of the prophages coding for ARGs, VFs (except one), and Toxins after characterization. These findings suggest that Geobacillus species could be a promising candidate for probiotic applications, offering potential advantages while minimizing the risks associated with prophage-mediated antimicrobial resistance and virulence factor transmission. Plasmids can impart new traits to probiotic bacteria, including enhancements in bacterial metabolism, adherence, and antibiotic resistance. However, if plasmids contribute antibiotic resistance to probiotic bacteria, this attribute is considered undesirable for a probiotic bacterium84. However, our study did not find any plasmid in the genomes of genus Geobacillus. We have also reported the same results previously in different studies18,50. The absence of mobile genetic elements, prophages, and plasmids reveals that the genomes of the genus Geobacillus are stable and good candidates as probiotics.
Bacteriocins, a diverse array of ribosomally synthesized antimicrobial peptides, provide probiotic bacteria with the advantageous ability to effectively combat other bacterial strains. They assist in the establishment of a producer bacterium within a specific environment, directly hinder the intrusion of competing strains or pathogens, and have the potential to alter the microbiota’s composition while influencing the host’s immune system85. Certain studies have documented the production of bacteriocins within the Bifidobacterium genus86. Similarly, several bacteriocins, including Circularin_A, ComX1, ComX4, Salivaricin_D, Sactipeptides, Pumilarin, and Geobacillin_I_like, were found across different genomes of Geobacillus. CRISPR-Cas systems are adaptive immune systems of microbes. These elements play a crucial role for bacteria in managing phage sequences found in the environment, particularly within the intricate ecosystem of the gut where a diverse viral community thrives. Phages can disrupt bacteria, significantly affecting the survival of bacterial populations, thereby impacting various parameters including the production of probiotics, fermentation duration, taste, and other essential factors87. Given the resilience of phages to pasteurization and the difficulty in eliminating them, the pursuit of probiotics possessing the capacity to shield against phages and other genetic intruders like plasmids becomes an urgent necessity. In a previous study, 77% of 48 analyzed species of Bifidobacterium possess CRISPR-Cas systems88. In our study, considering two prominent probiotic species of Bifidobacterium (B. breve and B. longum), we didn’t find any CRISPR-Cas-related genes. However, there were diverse genes related to CRISPR-Cas systems present in the genomes of Geobacillus such as Cas1, Cas2, Cas3, Cas4, Cas5h, Cas6, Cas9, Cmr1, Cmr3, Cmr4, Cmr5, and Cmr6. Thus, bacteriocins and CRISPR-Cas-related genes suggested the promising potential of probiotics among the genus Geobacillus.
A pivotal aspect of defining a probiotic strain is its stance on antibiotic resistance. Within the Qualified Presumption of Safety (QPS) criteria, evaluating probiotics involves examining their safety and antimicrobial resistance89. Ideally, probiotics should be susceptible to at least two antibiotics or lack inherent antimicrobial resistance90. The genotypic approach involves genome sequencing, including plasmids, to detect known antibiotic resistance (AR) genes. If these genes are surrounded by mobile elements or encoded within plasmids, it is advised against commercializing the strain. Safety considerations are crucial, especially if resistance involves clinically important antibiotics like vancomycin. The risk is lower if resistance affects less clinically relevant antibiotics, but thorough evaluation is needed before commercialization91. In our previous study18 we found that the genus Geobacillus is devoid of antibiotic resistance. The results collide with the findings of Puopolo and co-workers, where G. stearothermophilus GF16 isolated from the active volcanic area was susceptible to different antibiotics used (even at the lowest concentrations of 5 µg/mL)92. Likewise, the complete genome examination of G. thermoleovorans derived from geothermal springs indicates the lack of antimicrobial resistance genes93. These findings show the absence of antibiotic susceptibility in Geobacillus in general18. Similarly, in the present study, we only found two genes vanY and vanT related to vancomycin resistance. VanY acts as a D-carboxypeptidase, eliminating the terminal D-Ala from peptidoglycan to incorporate D-Lactate. The resulting D-Ala-D-Lac peptidoglycan subunits exhibit lower binding affinity with vancomycin than D-Ala-D-Ala. VanY is an “accessory” component in the Van cascade and isn’t an absolute necessity for vancomycin resistance94. Bifidobacterium and Lactobacillus genomes possess more genes apart from vanY and vanT such as ImrD, rpsL, and qacJ. A study has also reported the presence of erm, ileS, and rpoB genes in B. breve. Investigating the presence of virulence factors (including toxins and enzymes that could potentially heighten the microorganism’s pathogenicity) in the genome is crucial for identifying potential safety concerns. However, only a few toxin-like proteins and virulence factors are also absent in all the genomes of the genus Geobacillus. A few toxin-like proteins detected were PhoH, MazF, and PemK as compared to genus Bifidobacterium and Lactobacillus which possess an array of toxin-related genomes such as FitB, PemK, MazF, ParB, RelB, RelE, MraZ,YoeB, PhoH, and HipA. PhoH2 proteins in various microorganisms across bacteria and archaea comprise two domains: An N-terminal PIN-domain connected to a C-terminal PhoH domain. This fusion function as both an RNA helicase and ribonuclease. Mainly within mycobacteria, the genome encodes PhoH2 proteins alongside an adjacent gene, phoAT, believed to function as an antitoxin95. The mazEF module, found on Escherichia coli’s chromosome, serves as a stress-induced toxin-antitoxin system that triggers programmed cell death in E. coli. Precisely, mazF encodes a resilient toxin, whereas mazE encodes a comparatively less stable antitoxin96. In the Bacillus anthracis genome, a toxin-antitoxin (TA) module is present, consisting of pemI (antitoxin) and pemK (toxin). PemK functions as a powerful ribonuclease, demonstrating a preference for pyrimidines (specifically C and U) and operating as a translational attenuator97. Thus, compared to already known probiotic candidates of genus Bifidobacterium and Lactobacillus, the genus Geobacillus possesses very few toxin-like protein-coding genes. Thus, it has been proposed that the genus Geobacillus may be a good candidate with good probiotic potential.
Microbial genomes encode many genes responsible for Carbohydrate-active enzymes (CAZymes), whereas, in humans, only 17 relevant ones have been identified98. This discrepancy reveals that humans lack extensive enzyme machinery to utilize a wide array of complex carbohydrates. As a result, humans depend on a symbiotic co-metabolism with their microbiota to extract energy, particularly from otherwise indigestible carbohydrates99. The dynamic CAZyme profile is influenced by factors like available carbohydrates, non-carbohydrate food sources, delivery methods, and individual lifestyles100. Differences in host CAZymes or the lack of particular microbial species possessing distinct CAZymes can substantially impact how the host metabolizes various sources of carbohydrates101, impacting gut microbiota metabolism and potentially affecting host health. Assessing microbial genetic diversity (CAZy-typing) helps predict which carbohydrates the host can metabolize and identifies underrepresented CAZyme families that might require supplementation through microbiota transplantation or probiotics. Our study found an abundance of glycoside hydrolases followed by Glycosyl transferases and carbohydrate esterases among the genus Geobacillus. Thus, suggesting that they are capable of enzymatic degradation of various carbohydrates and consequently adding to the probiotic potential of these species. Thus, all the studied in silico features favour the probiotic nature of the genus Geobacillus. Yet, an assessment of in vitro characterization remains essential concerning probiotic attributes.
The unprecedented probiotic potential of the Geobacillus genus remains unexplored. With the Pan-Genome analysis’s advent, the intricate genetic makeup, the core genome concerning the essential function genes, and genes required to acclimatize in a new niche or secondary metabolite synthesis (conferred by the flexible genome) in a bacterium can be comprehensively disclosed. Analyzing the Pan-genome is a crucial method to provide insights into evolution and adaptation and explore potential probiotic characteristics in the group. Comparison to the genus Lactobacillus and Bifidobacterium in the current study revealed that the genus Geobacillus possesses an array of genes that aid in combatting stress conditions. Various genes conferring acidic tolerance and osmotic stress tolerance were found, with certain genes aiding in osmotic and oxidative stress tolerance confined to the genome of Geobacillus only. Determining the presence of mobile genetic elements (MGEs) remains paramount to instigating a strain with probiotic potential. Notably, Geobacillus appears stable, lacking mobile genetic elements (MGEs), antibiotic resistance genes, and mostly defective prophages. There were no observed plasmids, reducing the risk of horizontal gene transfer for antibiotic resistance. The presence of diverse bacteriocins and an abundance of CRISPR-Cas system genes in Geobacillus further suggests its potential against harmful elements like bacteriophages. Additionally, the prevalence of carbohydrate-active enzymes (CAZymes), especially glycoside hydrolases, glycosyl transferases, and carbohydrate esterases, hints at the ability of the genus Geobacillus to break down complex carbohydrates. This could enhance its potential as a probiotic, particularly in creating symbiotic food products when combined with prebiotics. Although this study highlights promising probiotic potential within the genus Geobacillus, additional in vitro and in vivo studies are important and required to validate these results. Overall, the comparative genomic analysis sheds light on Geobacillus' probiotic potential, yet empirical studies are imperative for substantiating these observations.
Due to its resilience and unique metabolic properties, Geobacillus holds significant promise as a probiotic in industrial and therapeutic applications. Its ability to thrive in extreme conditions makes it suitable for integration into industrial processes that require robust microbial performance, such as in the production of bioactive compounds, enzymes, and nutraceuticals. In therapeutic settings, Geobacillus could be leveraged to modulate gut microbiota, support digestive health, and combat gastrointestinal disorders, especially in challenging environments or populations with specific dietary needs. Its capacity to produce bacteriocins and withstand stress factors like acidity and bile further supports its application in developing next-generation probiotics tailored for specific health outcomes.
Future research should focus on in vivo studies to validate the safety and efficacy of Geobacillus strains in probiotic formulations, alongside trials assessing its impact on host microbiota and overall health. Additionally, exploring its potential in synergistic consortia with other probiotics could open new avenues for enhanced functionality. Investigating strain-specific genetic and metabolic pathways involved in host interaction and immune modulation would provide deeper insights into its therapeutic potential. A systems biology approach integrating omics technologies and bioengineering could refine its applications, making Geobacillus a cornerstone in industrial biotechnology and personalized probiotic therapies.
Data availability
The data analysed during the current study are available in the NCBI repository at https://www.ncbi.nlm.nih.gov/datasets/genome/. The following genomes with accession numbers have been studied and analysed in this study: Geobacillus_icigianus_G1w1__NZ_JPYA01000193, Geobacillus_kaustophilus_NBRC_102445__NZ_BBJV01000028, Geobacillus_jurassicus_NBRC_107829__BCQG00000000, Geobacillus_lituanicus_N-3__CP017692, Geobacillus_proteiniphilus_1017__NZ_MQMG00000000, Geobacillus_stearothermophilus_ATCC_12980__NZ_JYNW01000038, Geobacillus_subterraneus_KCTC3922__NZ_CP014342_1, Geobacillus_thermocatenulatus_BGSC_93A1__NEWK01000001, Geobacillus_thermodenitrificans_DSM_465__NZ_AYKT01000065, Geobacillus_thermoleovorans_SURF-48B__NZ_NAGD00000000, Geobacillus_uzenensis_BGSC_92A1__NZ_NEWL00000000, Geobacillus_sp._GHH01__NC_020210, Geobacillus_vulcani_PSS1__NZ_JPOI01000001, Geobacillus_sp._CAMR5420__NZ_JHUS00000000, Geobacillus_sp._Y412MC52__CP002442, Geobacillus_sp._C56-T3__NC_014206, Geobacillus_sp._LEMMJ02__NZ_VKJO00000000, Geobacillus_zalihae_JS1-2__CP129217, Lactobacillus_acidophilus_ATCC_9224__NZ_CP130437, Lactobacillus_delbrueckii_subsp._lactis_DSM_20072__CP022988, Lactiplantibacillus_plantarum_DSM_20174__CP039121, Bifidobacterium_breve_DSM_20213__BBAO00000000, Bifidobacterium_longum_subsp._infantis_ATCC_15697__CP001095.
References
Najar, I. N. & Thakur, N. A systematic review of the genera geobacillus and parageobacillus: Their evolution, current taxonomic status and major applications. Microbiology (United Kingdom) 166, 800–816 (2020).
Khaswal, A., Chaturvedi, N., Mishra, S. K., Kumar, P. R. & Paul, P. K. Current status and applications of genus Geobacillus in the production of industrially important products—a review. Folia Microbiol. 67, 389–404 (2022).
Novik, G., Savich, V. & Meerovskaya, O. Geobacillus bacteria: Potential commercial applications in industry, bioremediation, and bioenergy production. in Growing and Handling of Bacterial Cultures (IntechOpen, 2019). https://doi.org/10.5772/intechopen.76053.
Cortés-Antiquera, R., Márquez, S. L., Espina, G., Sánchez-SanMartín, J. & Blamey, J. M. Recombinant expression and characterization of a new laccase, bioinformatically identified, from the Antarctic thermophilic bacterium Geobacillus sp. ID17. Extremophiles https://doi.org/10.1007/s00792-023-01299-y (2023).
Meslé, M. M. et al. Isolation and characterization of lignocellulose-degrading geobacillus thermoleovorans from yellowstone national park. Appl. Environ. Microbiol. https://doi.org/10.1128/aem.00598-22 (2022).
Wada, K. & Suzuki, H. Biotechnological platforms of the moderate thermophiles, Geobacillus species: Notable properties and genetic tools. in Physiological and Biotechnological Aspects of Extremophiles 195–218 (Elsevier, 2020). https://doi.org/10.1016/B978-0-12-818322-9.00015-0.
Joe Shaw, A. et al. Metabolic engineering of a thermophilic bacterium to produce ethanol at high yield. PNAS 105, 13769–13774 (2008).
Christopher, L. P., Zambare, V. P., Zambare, A., Kumar, H. & Malek, L. A thermo-alkaline lipase from a new thermophile Geobacillus thermodenitrificans AV-5 with potential application in biodiesel production. J. Chem. Technol. Biotechnol. 90, 2007–2016 (2015).
Mir, M. Y., Hamid, S., Rohela, G. K., Parray, J. A. & Kamili, A. N. Composting and bioremediation potential of thermophiles. in Soil Bioremediation: An Approach Towards Sustainable Technology 143–174 (2021).
Mehta, R., Singhal, P., Singh, H. & Damle, D. Insight into thermophiles and their wide-spectrum applications. 3 Biotech 6, 1–9 (2016).
Choi, D. & Kong, M. LysGR1, a novel thermostable endolysin from Geobacillus stearothermophilus bacteriophage GR1. Front Microbiol https://doi.org/10.3389/fmicb.2023.1178748 (2023).
Ash, C., Farrow, J. A. E., Wallbanks, S. & Collins, M. D. Phylogenetic heterogeneity of the genus Bacillus revealed by comparative analysis of small-subunit-ribosomal RNA sequences. Lett. Appl. Microbiol. 13, 202–206 (1991).
Lin, J. H., Zhang, K. C., Tao, W. Y., Wang, D. & Li, S. Geobacillus strains that have potential value in microbial enhanced oil recovery. Appl. Microbiol. Biotechnol. 103, 8339–8350 (2019).
Donk, P. J. A highly resistant thermophilic organism. J. Bacteriol. 5(4), 373–374. https://doi.org/10.1128/jb.5.4.373-374.1920 (1920).
Nazina, T. N. et al. Taxonomic study of aerobic thermophilic bacilli: Descriptions of Geobacillus subterraneus gen. nov., sp. nov. and Geobacillus uzenensis sp. nov. from petroleum reservoirs and transfer of Bacillus stearothermophilus, B. thermocatenulatus, B. thermoleovorans. Int J Syst Evol Microbiol 51, 433–446 (2001).
Logan, N. A. The genus geobacillus. in The Prokaryotes: Firmicutes and Tenericutes vol. 9783642301 133–147 (Springer-Verlag Berlin Heidelberg, 2014).
Zebrowska, J. et al. Antimicrobial potential of the genera geobacillus and parageobacillus, as well as endolysins biosynthesized by their bacteriophages. Antibiotics 11(2), 242. https://doi.org/10.3390/antibiotics11020242 (2022).
Najar, I. N., Das, S., Kumar, S. & Sharma, P. Coexistence of heavy metal tolerance and antibiotic resistance in thermophilic bacteria belonging to genus geobacillus. Front Microbiol. 13, 1–15 (2022).
Jezewska-Frackowiak, J. et al. The promises and risks of probiotic Bacillus species. Acta. Biochim. Pol. 65, 509–519 (2018).
Łubkowska, B., Jeżewska-Frąckowiak, J., Sobolewski, I. & Skowron, P. M. Bacteriophages of thermophilic ‘bacillus group’ bacteria—a review. Microorganisms 9(7), 1522. https://doi.org/10.3390/microorganisms9071522 (2021).
Mahdhi, A., Hmila, Z., Behi, A. & Bakhrouf, A. Preliminary characterization of the probiotic properties of Candida famata and Geobacillus thermoleovorans. Iran. J. Microbiol. 3(3), 129–134 (2011).
Mcmullan, G. et al. Habitat, applications and genomics of the aerobic, thermophilic genus Geobacillus. Biochem. Soc. Trans. 32(Pt 2), 214–217. https://doi.org/10.1042/bst0320214.214-217Preprintat (2004).
Najar, I. N., Sherpa, M. T., Das, S., Das, S. & Thakur, N. Diversity analysis and metagenomic insights into antibiotic and metal resistance among Himalayan hot spring bacteriobiome insinuating inherent environmental baseline levels of antibiotic and metal tolerance. J. Glob. Antimicrob. Resist. 21, 342–352 (2020).
Donkor, E. S. Sequencing of bacterial genomes: Principles and insights into pathogenesis and development of antibiotics. Genes (Basel) 4, 556–572 (2013).
Saraswathy, N. & Ramalingam, P. Genome sequencing methods. Concepts and Techniques in Genomics and Proteomics, 95–107. https://doi.org/10.1533/9781908818058.95. in Concepts and Techniques in Genomics and Proteomics (eds. Saraswathy, N. & Ramalingam, P.) 95–107 (Woodhead Publishing, 2011). https://doi.org/10.1533/9781908818058.95.
Najar, I. N., Sherpa, M. T., Das, S. & Thakur, N. The draft genome sequence of Parageobacillus sp. strain SY1 gives insights into its physiological properties and protease production. Meta Gene 29, 100894 (2021).
Najar, I. N., Sherpa, M. T., Das, S. & Thakur, N. Bacterial diversity and functional metagenomics expounding the diversity of xenobiotics, stress, defense and CRISPR gene ontology providing eco-efficiency to Himalayan Hot Springs. Funct. Integr. Genomics 20, 479–496 (2020).
Caputo, A., Fournier, P. E. & Raoult, D. Genome and pan-genome analysis to classify emerging bacteria. Biol. Direct https://doi.org/10.1186/s13062-019-0234-0 (2019).
Tiwary, B. K. Chapter 3 - Evolutionary pan-genomics and applications. in Pan-genomics: Applications, Challenges, and Future Prospects (eds. Barh, D., Soares, S., Tiwari, S. & Azevedo, V.) 65–80 (Academic Press, 2020). https://doi.org/10.1016/B978-0-12-817076-2.00003-2.
Asif, M. et al. Comprehensive genomic analysis of Bacillus paralicheniformis strain BP9, pan-genomic and genetic basis of biocontrol mechanism. Comput. Struct. Biotechnol. J. 21, 4647–4662 (2023).
Bezuidt, O. K. et al. The Geobacillus pan-genome: Implications for the evolution of the genus. Front Microbiol. 7, 1–9 (2016).
Gurevich, A., Saveliev, V., Vyahhi, N. & Tesler, G. QUAST: Quality assessment tool for genome assemblies. Bioinformatics 29, 1072–1075 (2013).
Parks, D. H., Imelfort, M., Skennerton, C. T., Hugenholtz, P. & Tyson, G. W. CheckM: Assessing the quality of microbial genomes recovered from isolates, single cells, and metagenomes. Genome Res. 25, 1043–1055 (2015).
Bolger, A. M., Lohse, M. & Usadel, B. Trimmomatic: A flexible trimmer for Illumina sequence data. Bioinformatics 30, 2114–2120 (2014).
Langmead, B. & Salzberg, S. L. Fast gapped-read alignment with Bowtie 2. Nat. Methods 9, 357–359 (2012).
Arkin, A. P. et al. KBase: The United States department of energy systems biology knowledgebase. Nat. Biotechnol. 36, 566–569 (2018).
Olson, R. D. et al. Introducing the bacterial and viral bioinformatics resource center (BV-BRC): A resource combining PATRIC. IRD and ViPR. Nucleic Acids Res 51, D678–D689 (2023).
Seemann, T. Prokka: Rapid prokaryotic genome annotation. Bioinformatics 30, 2068–2069 (2014).
Carattoli, A. et al. In Silico detection and typing of plasmids using plasmidfinder and plasmid multilocus sequence typing. Antimicrob Agents Chemother 58, 3895–3903 (2014).
Grant, J. R. et al. Proksee: In-depth characterization and visualization of bacterial genomes. Nucleic Acids Res. 51, 484–492 (2023).
Liu, M. et al. ICEberg 2.0: An updated database of bacterial integrative and conjugative elements. Nucleic Acids Res. 47, D660–D665 (2019).
Wang, M. et al. VRprofile2: Detection of antibiotic resistance-associated mobilome in bacterial pathogens. Nucleic Acids Res. 50, W768–W773 (2022).
Van Heel, A. J. et al. BAGEL4: A user-friendly web server to thoroughly mine RiPPs and bacteriocins. Nucleic Acids Res. 46, W278–W281 (2018).
Couvin, D. et al. CRISPRCasFinder, an update of CRISRFinder, includes a portable version, enhanced performance and integrates search for Cas proteins. Nucleic Acids Res. 46, W246–W251 (2018).
Alcock, B. P. et al. CARD 2020: Antibiotic resistome surveillance with the comprehensive antibiotic resistance database. Nucleic Acids Res. 48, D517–D525 (2020).
Pei, Z. et al. Comprehensive scanning of prophages in lactobacillus: Distribution, diversity, antibiotic resistance genes, and linkages with CRISPR-Cas systems. mSystems 6(3), 10–1128 (2021).
Akarsu, H. et al. TASmania: A bacterial toxin-antitoxin systems database. PLoS Comput. Biol. 15, 1–28 (2019).
Yin, Y. et al. DbCAN: A web resource for automated carbohydrate-active enzyme annotation. Nucleic Acids Res. 40, 445–451 (2012).
Liu, D. et al. IPGA: A handy integrated prokaryotes genome and pan-genome analysis web service. iMeta 1, 1–7 (2022).
Najar, I. N., Das, S. & Thakur, N. Reclassification of Geobacillus galactosidasius and Geobacillus yumthangensis as Parageobacillus galactosidasius comb. nov. and parageobacillus yumthangensis comb. Nov., respectively. Int. J. Syst. Evol. Microbiol. 70, 6518–6523 (2020).
Wang, M. et al. Pan-genome analyses of geobacillus spp. reveal genetic characteristics and composting potential. Int. J. Mol. Sci. 21, 1–16 (2020).
Foongsawat, N. et al. Isolation, characterization, and comparative genomics of the novel potential probiotics from canine feces. Food Sci. Anim. Resour. 43, 685–702 (2023).
Binda, S. et al. Criteria to qualify microorganisms as “Probiotic” in foods and dietary supplements. Front Microbiol. 11, 1–9 (2020).
Zhao, X. et al. Collagen-like proteins (ClpA, ClpB, ClpC, and ClpD) are required for biofilm formation and adhesion to plant roots by Bacillus amyloliquefaciens FZB42. PLoS ONE 10, 1–16 (2015).
Lee, J. & Sullivan, D. J. O. Genomic insights into bifidobacteria. Microbiol. Mol. Biol. Rev. 74, 378–416 (2010).
Connell, M. O., Zomer, A., Leahy, S. C., Reunanen, J. & Bottacini, F. Functional genome analysis of Bi fi dobacterium breve UCC2003 reveals type IVb tight adherence (Tad) pili as an essential and conserved host-colonization factor. PNAS 108, 11217–11222 (2011).
Nguyen, T. L. & Kim, D. Genome-wide comparison reveals a probiotic strain lactococcus lactis WFLU12 isolated from the gastrointestinal tract of olive flounder (Paralichthys olivaceus) Harboring Genes supporting probiotic action. Mar. Drugs 16, 1–17 (2018).
Nakamura, T. et al. Identification of pyrC gene as an immunosuppressive factor in Francisella novicida infection. Front Cell Infect. Microbiol. https://doi.org/10.3389/fcimb.2022.1027424 (2022).
Jane, M. Characterisation of the xanthine-uanine phosphoribosyltransferase of helicobacter pylori as a potential therapeutic target. (1968) https://doi.org/10.26190/unsworks/17946
Kholti, A. et al. PyrH-Encoded UMP-Kinase directly participates in pyrimidine-specific modulation of promoter activity in escherichia coli. J. Mol. Biology 280(4), 571–582. https://doi.org/10.1006/jmbi.1998.1910 (1998).
Jurado-Martín, I., Sainz-Mejías, M. & McClean, S. Pseudomonas aeruginosa: An audacious pathogen with an adaptable arsenal of virulence factors. Int. J. Mol. Sci. 22, 1–37 (2021).
Yoshida, T., Nasu, H., Namba, E., Ubukata, O. & Yamashita, M. Discovery of a compound that acts as a bacterial PyrG (CTP synthase) inhibitor. J. Med. Microbiol. 61, 1280–1285 (2012).
Fields, C. J. & Switzer, R. L. Regulation of pyr gene expression in Mycobacterium smegmatis by PyrR-dependent translational repression. J. Bacteriol. 189, 6236–6245 (2007).
Ferrari, B. & Peyvandi, F. How I treat thrombotic thrombocytopenic purpura in pregnancy. Blood 136, 2125–2132 (2020).
Pires, D. et al. Modulation of Cystatin C in human macrophages improves anti-mycobacterial immune responses to mycobacterium tuberculosis infection and coinfection with HIV. Front Immunol https://doi.org/10.3389/fimmu.2021.742822 (2021).
Blancas-Luciano, B. E. et al. Antimicrobial and anti-inflammatory activity of Cystatin C on human gingival fibroblast incubated with Porphyromonas gingivalis. PeerJ 10, e14232 (2022).
Sturgill, G., Toutain, C. M., Komperda, J., O’Toole, G. A. & Rather, P. N. Role of CysE in production of an extracellular signaling molecule in Providencia stuartii and Escherichia coli: Loss of cysE enhances biofilm formation in Escherichia coli. J Bacteriol 186, 7610–7617 (2004).
Kriel, A. et al. GTP dysregulation in Bacillus subtilis cells lacking (p)ppGpp results in phenotypic amino acid auxotrophy and failure to adapt to nutrient downshift and regulate biosynthesis genes. J Bacteriol 196, 189–201 (2014).
Crona, M. et al. NrdH-redoxin protein mediates high enzyme activity in manganese- reconstituted ribonucleotide reductase from Bacillus anthracis. J. Biol. Chem. 286, 33053–33060 (2011).
Nikolopoulos, N. et al. DltC acts as an interaction hub for AcpS, DltA and DltB in the teichoic acid d-alanylation pathway of Lactiplantibacillus plantarum. Sci. Rep. https://doi.org/10.1038/s41598-022-17434-2 (2022).
Domogalla, M. P., Rostan, P. V., Raker, V. K. & Steinbrink, K. Tolerance through education: How tolerogenic dendritic cells shape immunity. Front. Immunol. https://doi.org/10.3389/fimmu.2017.01764 (2017).
Chou, L. & Weimer, B. Isolation and Characterization of Acid- and Bile-Tolerant Isolates from Strains of Lactobacillus acidophilus. J. Dairy Sci. 82, 23–31 (1999).
Ventura, M., Canchaya, C., Sinderen, D. V., Fitzgerald, G. F. & Zink, R. Bifidobacterium lactis DSM 10140: Identification of the atp (atpBEFHAGDC ) operon and analysis of its genetic structure, characteristics, and phylogeny. Appl. Environ. Microbiol. 70, 3110–3121 (2004).
Duary, R. K., Batish, V. K. & Grover, S. Expression of the atpD gene in probiotic Lactobacillus plantarum strains under in vitro acidic conditions using RT-qPCR. Res. Microbiol. 161, 399–405 (2010).
Fraser, K. R., Harvie, D., Coote, P. J. & O’Byrne, C. P. Identification and characterization of an ATP binding cassette L-carnitine transporter in Listeria monocytogenes. Appl. Environ. Microbiol. 66, 4696–4704 (2000).
Kempf, B. & Bremer, E. OpuA, an osmotically regulated binding protein-dependent transport system for the osmoprotectant glycine betaine in Bacillus subtilis. J. Biol. Chem. 270, 16701–16713 (1995).
Shamsuzzaman, M., Dahal, R. H., Kim, S. & Kim, J. Genome insight and probiotic potential of three novel species of the genus Corynebacterium. Front Microbiol. 14, 1–14 (2023).
Méndez, V., Rodríguez-Castro, L., Durán, R. E., Padrón, G. & Seeger, M. The OxyR and SoxR transcriptional regulators are involved in a broad oxidative stress response in Paraburkholderia xenovorans LB400. Biol. Res. 55, 1–19 (2022).
Pfeiler, E. A., Azcarate-Peril, M. A. & Klaenhammer, T. R. Characterization of a novel bile-inducible operon encoding a two-component regulatory system in Lactobacillus acidophilus. J. Bacteriol. 189, 4624–4634 (2007).
Bačun-Družina, V., Mrvčić, J., Butorac, A. S., Stehlik-Tomas, V. & Gjuračić, K. The influence of gene transfer on the lactic acid bacteria evolution. Mljekarstvo 59, 181–192 (2009).
Sylvere, N. et al. Whole-genome sequence analysis and probiotic characteristics of Lactococcus lactis Subsp. lactis strain Lac3 isolated from traditional fermented buffalo milk (Dadih). J. Genetic Eng. Biotechnol. 21, 1–12 (2023).
Valdez-Baez, J. et al. Comparative genomics and in silico evaluation of genes related to the probiotic potential of bifidobacterium breve 110 1A. Bacteria 2022, 161–182 (2022).
Pei, Z. et al. A universe of human gut-derived bacterial prophages: Unveiling the hidden viral players in intestinal microecology. Gut. Microbes. https://doi.org/10.1080/19490976.2024.2309684 (2024).
Abriouel, H. et al. New insights into the role of plasmids from probiotic Lactobacillus pentosus MP-10 in Aloreña table olive brine fermentation. Sci. Rep. 9, 1–19 (2019).
Dobson, A., Cotter, P. D., Paul Ross, R. & Hill, C. Bacteriocin production: A probiotic trait?. Appl. Environ. Microbiol. 78, 1–6 (2012).
Sarkar, A. & Mandal, S. Bifidobacteria—Insight into clinical outcomes and mechanisms of its probiotic action. Microbiol. Res. 192, 159–171 (2016).
Yang, L. et al. Occurrence and diversity of CRISPR loci in lactobacillus casei group. Front Microbiol. 11, 1–9 (2020).
Briner, A. E. et al. Occurrence and diversity of CRISPR-Cas systems in the genus bifidobacterium. PLoS ONE 10, 1–16 (2015).
Koutsoumanis, K. et al. Update of the list of QPS-recommended biological agents intentionally added to food or feed as notified to EFSA 15: Suitability of taxonomic units notified to EFSA until September 2021. EFSA J. 20, 1–40 (2022).
Borriello, S. P. et al. Safety of probiotics that contain lactobacilli or bifidobacteria. Clin. Infect. Dis. 36, 775–780 (2003).
Merenstein, D. et al. Emerging issues in probiotic safety: 2023 perspectives. Gut Microbes 15, 1–22 (2023).
Puopolo, R. et al. Identification of a new heavy-metal-resistant strain of Geobacillus stearothermophilus isolated from a hydrothermally active volcanic area in southern Italy. Int. J. Environ. Res. Public Health 17, 2678 (2020).
Oztug, M., Cebeci, A., Mumcu, H., Akgoz, M. & Karaguler, N. G. Whole-genome sequence of geobacillus thermoleovorans ARTRW1, isolated from armutlu geothermal spring. Turkey. https://doi.org/10.1128/MRA (2020).
Arthur, M., Depardieu, F., Snaith, H. A., Reynolds, P. E. & Courvalin, P. Contribution of vanY D, D-carboxypeptidase to glycopeptide resistance in Enterococcus faecalis by hydrolysis of peptidoglycan precursors. Antimicrob. Agents Chemother. 38, 1899–1903 (1994).
Andrews, E. S. V. & Arcus, V. L. PhoH2 proteins couple RNA helicase and RNAse activities. Protein Sci. 29, 883–892 (2020).
Amitai, S., Yassin, Y. & Engelberg-Kulka, H. MazF-mediated cell death in Escherichia coli: A point of no return. J Bacteriol 186, 8295–8300 (2004).
Agarwal, S., Mishra, N. K., Bhatnagar, S. & Bhatnagar, R. PemK toxin of Bacillus anthracis is a ribonuclease: An insight into its active site, structure, and function. J. Biol. Chem. 285, 7254–7270 (2010).
Kaoutari, A. E., Armougom, F., Gordon, J. I., Raoult, D. & Henrissat, B. The abundance and variety of carbohydrate-active enzymes in the human gut microbiota. Nat. Rev. Microbiol. 11, 497–504 (2013).
Soverini, M. et al. Variation of carbohydrate-active enzyme patterns in the gut microbiota of Italian healthy subjects and type 2 diabetes patients. Front Microbiol. 8, 1–8 (2017).
Ye, L., Das, P., Li, P., Ji, B. & Nielsen, J. Carbohydrate active enzymes are affected by diet transition from milk to solid food in infant gut microbiota. FEMS Microbiol. Ecol. 95, 1–9 (2019).
Aakko, J. et al. A carbohydrate-active enzyme (CAZy) profile links successful metabolic specialization of Prevotella to its abundance in gut microbiota. Sci. Rep. 10, 1–12 (2020).
Acknowledgements
Dr Ishfaq Nabi Najar would like to thank DBT-RA, Department of Biotechnology, Govt. of India, for providing the DBT-RA Fellowship (DBT-RA/2022/JULY/N/2877) for research work. I would also like to thank CSIR IIIM Jammu for providing me with lab space to conduct my research.
Funding
Not applicable.
Author information
Authors and Affiliations
Contributions
Ishfaq Nabi Najar: Conceptualization, Data Curation, Analysis, Writing – original draft. Prayatna Sharma: Analysis and Writing– original draft. Rohit Das: Analysis and Editing – original draft. Krishnendu Mondal, Ashish Kumar Singh, Anu Radha, Varsha Sharma, Sonali Sharma- Data Curation, Writing and Editing – original draft, Nagendra Thakur: Review & Editing. Sumit G Gandhi: Review & Editing. Vinod Kumar: Conceptualization, Review & Editing.
Corresponding author
Ethics declarations
Competing interests
The authors declare no competing interests.
Ethical approval
Not applicable.
Additional information
Publisher’s note
Springer Nature remains neutral with regard to jurisdictional claims in published maps and institutional affiliations.
Supplementary Information
Rights and permissions
Open Access This article is licensed under a Creative Commons Attribution-NonCommercial-NoDerivatives 4.0 International License, which permits any non-commercial use, sharing, distribution and reproduction in any medium or format, as long as you give appropriate credit to the original author(s) and the source, provide a link to the Creative Commons licence, and indicate if you modified the licensed material. You do not have permission under this licence to share adapted material derived from this article or parts of it. The images or other third party material in this article are included in the article’s Creative Commons licence, unless indicated otherwise in a credit line to the material. If material is not included in the article’s Creative Commons licence and your intended use is not permitted by statutory regulation or exceeds the permitted use, you will need to obtain permission directly from the copyright holder. To view a copy of this licence, visit http://creativecommons.org/licenses/by-nc-nd/4.0/.
About this article
Cite this article
Najar, I.N., Sharma, P., Das, R. et al. Unveiling the probiotic potential of the genus Geobacillus through comparative genomics and in silico analysis. Sci Rep 15, 33748 (2025). https://doi.org/10.1038/s41598-025-98392-3
Received:
Accepted:
Published:
DOI: https://doi.org/10.1038/s41598-025-98392-3